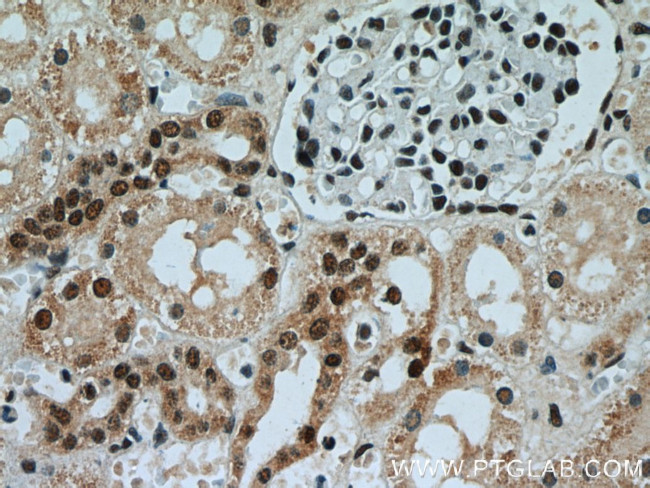
AQR Antibody in Immunohistochemistry (Paraffin) (IHC (P))

Search
Proteintech
AQR Polyclonal Antibody
{{$productOrderCtrl.translations['antibody.pdp.commerceCard.promotion.promotions']}}
{{$productOrderCtrl.translations['antibody.pdp.commerceCard.promotion.viewpromo']}}
{{$productOrderCtrl.translations['antibody.pdp.commerceCard.promotion.promocode']}}: {{promo.promoCode}} {{promo.promoTitle}} {{promo.promoDescription}}. {{$productOrderCtrl.translations['antibody.pdp.commerceCard.promotion.learnmore']}}
产品信息
24342-1-AP
种属反应
宿主/亚型
分类
类型
抗原
偶联物
形式
浓度
规格
纯化类型
保存液
内含物
保存条件
运输条件
产品详细信息
Immunogen sequence: QGRARASLC NLYNWRYKNL GNLPHVQLLP EFSTANAGLL YDFQLINVED FQGVGESEPN PYFYQNLGEA EYVVALFMYM CLLGYPADKI SILTTYNGQK HLIRDIINRR CGNNPLIGRP NKVTTVDRFQ GQQNDYILLS LVRTRAVGHL RDVRRLVVAM SRARLGLYIF ARVSLFQNCF ELTPAFSQLT ARPLHLHIIP TEPFPTTRKN GERPSHEVQI IKNMPQMANF VYNMYMHLIQ TTHHYHQTLL QLPPAMVEEG EEVQNQETEL ETEEEAMTVQ ADIIPSPTDT SCRQETPAFQ TDTTPSETGA TSTPEAIPAL SETTPTVVGA VSAPAEANTP QDATSAPEET K (1136-1485 aa encoded by BC127111)
靶标信息
Involved in pre-mRNA splicing as component of the spliceosome (PubMed:11991638, PubMed:25599396, PubMed:28502770, PubMed:28076346). Intron-binding spliceosomal protein required to link pre-mRNA splicing and snoRNP (small nucleolar ribonucleoprotein) biogenesis (PubMed:16949364). Plays a key role in position-dependent assembly of intron-encoded box C/D small snoRNP, splicing being required for snoRNP assembly (PubMed:16949364). May act by helping the folding of the snoRNA sequence. Binds to intron of pre-mRNAs in a sequence-independent manner, contacting the region between snoRNA and the branchpoint of introns (40 nucleotides upstream of the branchpoint) during the late stages of splicing (PubMed:16949364). Has ATP-dependent RNA helicase activity and can unwind double-stranded RNA molecules with a 3' overhang (in vitro) (PubMed:25599396). [UniProt]
仅用于科研。不用于诊断过程。未经明确授权不得转售。
生物信息学
蛋白别名: aquarius homolog; functional spliceosome-associated protein 164; IBP160; intron-binding protein aquarius; Intron-binding protein of 160 kDa; RNA helicase aquarius; unnamed protein product
基因别名: AQR; fSAP164; IBP160; KIAA0560
UniProt ID: (Human) O60306
Entrez Gene ID: (Human) 9716